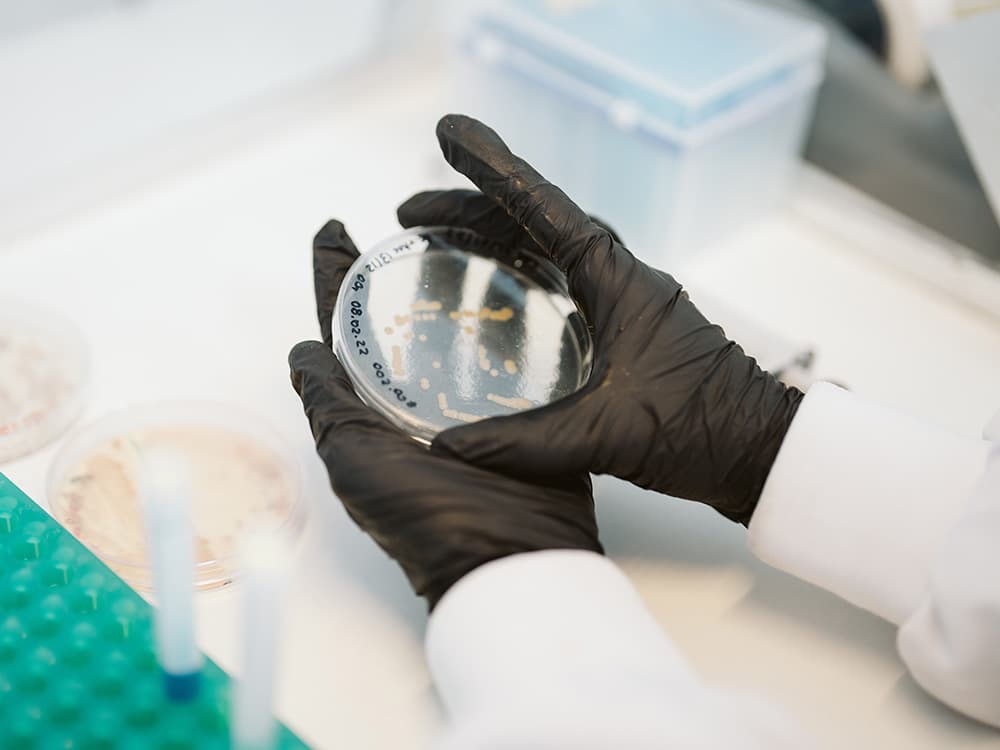

A design platform
bringing life to materials.
What we do
We build upon 3.8 billion years of microbial evolution to craft a new class of biomaterials, designed to displace animal leathers and plastic-based synthetic textiles.

How we do it
Our proprietary process combines biology, chemistry, engineering and design to produce materials that deliver on quality, performance, and impact.
Our platform connects the dots between

Biology
Harnessing the natural abilities of microbes with the latest biological tools to produce a highly adaptable natural fiber called nanocellulose

Material Science
Exploring the boundaries of nanomaterials, fiber science and green chemistry to reimagine what bio-based materials are capable of

Engineering
Designing the tools and systems to enable pathways to true circularity, we create new material systems with scale and accessibility in mind

Craft
Building on centuries of textile craft, we collaborate with skilled artisans and industry experts to ensure the highest level of quality and workability
An evolving material platform, unlocking infinite design possibilities

Korvaa Consortium unites three biomaterial technologies
Designboom, June 2025
The Korvaa Consortium unveils the world’s first shoe made from a novel combination of mycelium, bacterial nanocellulose, and bio-based PHAs. The concept shoe unites three leading biomaterial technologies for the first time, mirroring nature’s approach to solve complex design challenges through purposeful, biologically-derived material selection.

Modern Synthesis secures $5.5M from leading investors
Press Release, Feb 2024
Modern Synthesis, a biotechnology company pioneering microbially-derived biomaterials, announces the successful close of a $5.5 million funding round. The oversubscribed round was led by Extantia Capital, with participation from Artesian and Collaborative Fund. This investment will enable Modern Synthesis to expand production at its pilot facility and service more brands on its waitlist.

Could this be the leather of the future?
CNN, May 2024
Start-up Modern Synthesis is creating new materials by working with living organisms – bacteria. The aim is to create low-carbon alternatives to traditional fabrics, curbing emissions and plastic pollution. “For the first time, we’re able to offer the aesthetic and performance of the materials that we use everyday but without the plastic and without the animal. I can’t stress how hard that is.”
Technology
Reinventing materials





The result: a revolutionary class of biomaterials which can be tuned to displace a spectrum of textiles, from plastic films to leathers.

Microcraft
Redefining textile craft, from the nanoscale. Inspiring the senses with the exceptional strength, refined beauty and tactility of nanocellulose, this new class of materials unlocks new design possibilities, bringing life to a new era of luxury.

Performance from nature
The next generation of performance – without plastic. Our technology offers a scalable, highly adaptable alternative to synthetic coated materials with the intrinsic performance advantages of nanocellulose.
Impact
Reimagining systems



Our evolving biotechnology process addresses 5 related challenges: GHG emissions, waste, land use, plastic pollution and animal welfare.
Nature has had 3.8 billion years to perfect the ultimate circular economy: life.

Designed for scale
Our process is driven by impact and designed for scale. As our production capacity grows, we plan to leverage existing manufacturing equipment, optimise material design processes for scale, and collaborate with knowledgable ecosystem partners.

Butterfly Mark certified
Modern Synthesis is officially the first material supplier to be certified by Positive Luxury. The Butterfly Mark is only ever awarded to brands that meet higher and higher standards for people and nature – giving our partners assurance that we are actively investing in raising industry standards, not just meeting them. And while we’re proud of how far we’ve come in this journey, we know the real work is just beginning. That means, as standards rise, we’re committed to continually improving our performance.
Team
Human-powered innovation
As a team of biologists, chemists, designers, engineers, storytellers, strategists, and microbes, we are living proof that breakthroughs happen when disparate disciplines, perspectives and ideas collide.
Founders

Our Founders: Dr. Ben Reeve (CTO) and Jen Keane (CEO)
The first seeds of Modern Synthesis’ future were planted during our Co-founder Jen’s Central Saint Martins MA project, This is Grown. Jen’s Previous work at adidas and Nike inspired her to re-envision the product design process by growing the upper of an athletic shoe with only bacterial nanocellulose and one continuous yarn. While working on This Is Grown, she collaborated closely with scientists from Imperial College London, including our Co-founder Ben, who discovered and sequenced the strain of bacteria that we employ to produce our novel biomaterials today.
With a PhD in bioengineering and previous experiences as the founding CTO of Puraffinity, Ben’s technology vision proved to be the perfect complement to Jen’s design ambitions. Their collaboration was both a response to our ongoing plastic crisis and an attempt to prove the profound design and performance possibilities of new biomaterial technologies. Now at the helm of Modern Synthesis, they remain united by the idea that sustainability, technology, creativity, and beauty can – and should – go hand in hand.
Leadership

Patricia Ahufinger
Vice President of Operations
With supply chain expertise spanning continents and companies of all sizes, Patricia builds the systems that turn bold ideas into smooth operations.

Sarah West Young
Head of Growth
An Oxford MBA strategist in mind and a storyteller at heart, Sarah brings big-picture thinking to the commercial partnerships fuelling the future of materials.

Dr. Neil Buckney, PhD
Head of Engineering
A composites specialist and ex-EV engineering lead, Neil is reimagining how materials are made – and how they move through manufacturing flows at scale.

Dr. Ioannis Zampetakis, PhD
Head of Science
A bioprocess engineer with a PhD in biomaterials, Ioannis brings scientific rigour and a passion for progress to the science advancing next-gen materials.
Values

We co-culture change
Co-Culture reflects our commitment to cross-pollination internally and externally, our ability to lean on one another, and our role as a catalyst in both business and culture

We put growth on a pedestal
Growth speaks to our inspiration and creative use of biology, our bias towards impact and scale, and our dedication to empowering industry to ‘grow up’ from a harmful past

We do it all by design
By Design articulates the intentionality, empathy, and creativity built into all aspects of our work. It also speaks to the importance of accountability and core design thinking principles
FAQs


FAQs
Curious to know more about our materials? You can explore answers to all of our most commonly asked questions on our FAQ page below – and if your question isn’t listed you’re always welcome to drop us a line at hello@modernsynthesis.com.
Team
Open positions
General Application
About the role
If we don’t have a role that suits your experience, you can submit a general application here.
Working at Modern Synthesis requires comfort with rapid innovation cycles and constant growth that comes with working in a start-up. You will need to be proactive and flexible to take on new tasks and challenges, whilst upholding our passion for sustainability and impact.
News
Reframing the narrative

Korvaa Consortium unites three biomaterial technologies
Designboom, June 2025
The Korvaa Consortium unveils the world’s first shoe made from a novel combination of mycelium, bacterial nanocellulose, and bio-based PHAs. The concept shoe unites three leading biomaterial technologies for the first time, mirroring nature’s approach to solve complex design challenges through purposeful, biologically-derived material selection.

Modern Synthesis receives Butterfly Mark certification
Positive Luxury, March 2025
Modern Synthesis is officially Butterfly Mark certified – making us the first material supplier to meet Positive Luxury’s rigorous ESG+ (Environmental, Social, Governance & Innovation) standards. To certify, we had to pass an expert-led, independent assessment which is built on the foundation of international agreements, global frameworks and standards, and even potential upcoming legislation.

Modern Synthesis secures $5.5M from leading investors
Press Release, Feb 2024
Modern Synthesis, a biotechnology company pioneering microbially-derived biomaterials, announces the successful close of a $5.5 million funding round. The oversubscribed round was led by Extantia Capital, with participation from Artesian and Collaborative Fund. This investment will enable Modern Synthesis to expand production at its pilot facility and service more brands on its waitlist.

The biotech company creating fashion with bacteria
Parley for the Oceans, May 2024
In an unassuming laboratory on an industrial estate in South West London is a shoe that’s been grown from bacteria. This new way of approaching material design is organism-led, a technique that collaborates with the origins of life on Earth in order to help design its future. Parley visited the Modern Synthesis lab in London to get a firsthand look at the products they’re making using K.Rhaeticus bacteria.

Could this be the leather of the future?
CNN, May 2024
Start-up Modern Synthesis is creating new materials by working with living organisms – bacteria. The aim is to create low-carbon alternatives to traditional fabrics, curbing emissions and plastic pollution. “For the first time, we’re able to offer the aesthetic and performance of the materials that we use everyday but without the plastic and without the animal. I can’t stress how hard that is.”

Meet the founder: Jen Keane
AgFunder News, January 2024
Modern Synthesis combines nanocellulose created by sugar-eating bacteria, with natural textiles. According to Keane, the process is “similar to how rebar is used to reinforce concrete” and generates materials that “can be processed on the same equipment as conventional textiles.” But how efficient are bugs at creating bags, and how scalable is Modern Synthesis’ patent-pending technology?

GANNI unveils bag made from bacterial leather at LDF
Dezeen, September 2023
Bacteria were used to form this one-off edition of the Bou Bag by Danish fashion brand GANNI, made from a leather alternative by London biotech company Modern Synthesis that contains no plastic or petrochemicals. “Collaborating with GANNI on the Bou Bag has allowed us to showcase the viability of bacterial cellulose-based materials in real-world applications,” said Modern Synthesis CEO Jen Keane.

GANNI and Modern Synthesis made a Bou Bag
Futurevvorld, September 2023
Unveiled at London Design Week 2023, the collaboration reimagines GANNI’s much-loved “Bou Bag” – previously made from a mix of materials, including recycled leather, polyurethane, recycled cotton and polyester – in Modern Synthesis’ bacteria-based alternative material, bacterial nanocellulose, described as “a particularly strong and fine form of cellulose derived from bacterial fermentation.”

Growing a biomaterial future with Jen Keane
WGSN, April 2023
Jen Keane joins WGSN on their Create Tomorrow podcast to discuss what’s next for biomaterials and what brands can do to work collaboratively with startups in this field. “It’s a replacement for leather, but it doesn’t feel exactly like leather and it doesn’t behave exactly like leather. These materials are really new and can help us design products differently and we need to approach them that way.”

These textiles were grown by bacteria
Fast Company, April 2023
Modern Synthesis has developed a novel way to create textiles from a microbe, and the resulting material could be sold to brands as a replacement for synthetic fabrics. “It’s naturally transparent, and it almost looks like a nylon or technical synthetic fabric,” Jen Keane says. “But the feel is much more natural. And it’s adaptable in terms of its hand feel.” It can be more flexible, for example, or thicker…

Modern Synthesis raises $4.1 million
AgFunder News, July 2022
UK-based biomaterials startup Modern Synthesis has raised $4.1 million in seed funding to support its microbial textile platform that aims to make the fashion industry more sustainable. Investors in the round include AgFunder, Collaborative Fund, Acequia Capital, Petri Bio, Ponderosa Ventures, Possible Ventures, IMO Ventures, Taihill Venture, and Parley for the Oceans, amongst others.

Cellulose shoes made by bacteria
Nature Biotechnology, August 2022
Modern Synthesis’ goal is to produce a new class of material, a composite material that will replace animal-and petrochemical-made sneakers with a biodegradable, yet durable, alternative. The shoe’s upper is made by bacteria that naturally produce nanocellulose (Komagataeibacter rhaeticus). They can be genetically engineered to self-dye by producing melanin for color.


















